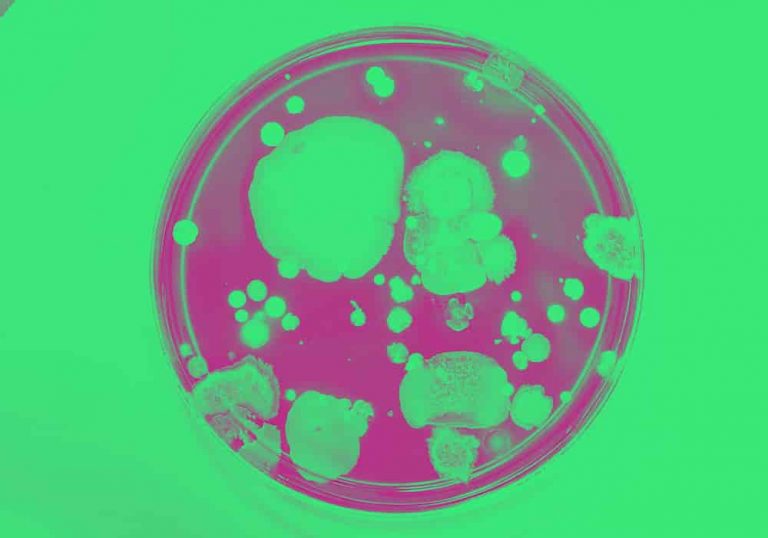

“Antibiotic” vs. “Abiotic” vs. “Antibody”: What Is The Difference?
by John Kelly, Senior Research Editor at Dictionary.com
In our article on virus vs. bacteria, we noted that vaccines can work on both viruses and bacteria. Antibiotics, however, are only effective against bacteria.
But what is an antibiotic, exactly, and how is it different from another, frustratingly similar word: abiotic? And how do both of these words compare to antibody and antigen?
This is a confusing set of words, but the differences between them aren’t, well, rocket science. It actually comes down pharmacology, immunology, and ecology.
What does antibiotic mean?
Antibiotics are medicines used to fight bacterial infections. They do not work against viruses. But let’s get a little more technical. Antibiotics are kind of a big deal, after all.
Antibiotics are chemical substances produced by microorganisms and fungi. When properly prepared, these substances can inhibit the growth of (or destroy) bacteria and other microorganisms.
There are many types of antibiotics, and while we may take them for granted today, they completely transformed modern health and medicine by providing a cure for many kinds of previously deadly infections.
Considered the first true antibiotic, penicillin was discovered in 1928 by Scottish scientist Alexander Fleming. It’s a famous tale: returning to his laboratory after a vacation, Fleming noticed mold had invaded a petri dish in which he was culturing some bacteria. But around the mold, the bacteria wasn’t growing.
That mold was Penicillium notatum, and Fleming determined it contained an antibacterial agent he called penicillin. Thanks to the subsequent work of several other brilliant scientists, penicillin was developed and introduced across the world as a medicine in the early 1940s.
Now, check this out. While they didn’t know the science of it as we do today, ancient civilizations did harness the power of naturally occurring antibiotic substances to help treat infections. There are references to the benefits of applying moldy bread on wounds in ancient Egypt, China, Greece, Rome, and Serbia.
Moldy bread!
Today, antibiotics are prescribed to treat many infections, commonly including strep throat, UTIs, and some sinus and ear infections. However, doctors are wary of the overuse of antibiotics because bacteria can develop resistance to them, which makes those infections harder to treat.
Antibiotic vs. antibacterial
Antibacterial means “destructive to or inhibiting the growth of bacteria.” That means all antibiotics can be said to be antibacterial.
But not all antibacterial substances are antibiotics. Most antibacterial soaps, for instance, are made with a chemical called triclosan, which can kill bacteria. But triclosan is synthetic; antibiotics, remember, are substances specifically produced by microorganisms.
Good to note: many doctors and scientists recommend using plain soap and water over antibacterial soap because, among other reasons, antibacterial soaps can kill good bacteria along with harmful ones and can contribute to antibiotic resistance.
Where does antibiotic come from?
Etymologically speaking, you could say antibiotic literally means “against living things”—which you might find ironic for something that has saved so many lives. The kind of “life” meant in the word antibiotic isn’t any old organism, like you or us or Fido or Flipper, though: it’s microbes.
In its medical sense, the adjective antibiotic is recorded in the 1890s, based on the French antibiotique. Since the 1940s, antibiotic has been used as a noun, the principal way it is used today.
The prefix anti- means “against, opposing.” The word biotic, “pertaining to life,” ultimately goes back, via Latin, to the Greek biōtikós. As you may have deduced, biotic is related to bio–, as in biology (“study of life”) and biography (“life-writing”).
What does abiotic mean?
Abiotic means “of or characterized by the absence of life or living organisms.” Like antibiotic, abiotic contains the element biotic. As we saw, this means “related to life,” and ultimately derives from Greek roots. The prefix a- is also from Greek, and it means “not, without.” So, abiotic literally means “nonliving.”
The word abiotic frequently appears in abiotic factor, a term used in ecology for “a part of an environment or ecosystem that isn’t live,” such as rain, sunshine, and rocks. Abiotic factor is generally used in contrast to biotic factor, “or any living thing that has an effect on an ecosystem.” Biotic factors are living parts (the organisms) of that ecosystem, and abiotic factors are nonliving parts (often, the habitat).
Outside water and sunlight, some other examples of abiotic factors that can make a difference in the life of an organism are: water salinity (salt content), wind, temperature, elevation, soil type, radiation, and pollution.
Dig deeper into biotic factor and antibiotic factor with our Homework Help articles on the terms.
How to tell antibiotic and abiotic part
If you aren’t sure if antibiotic or abiotic is the right word to use, ask yourself:
- Is the context concerning health and medicine? If yes, then you probably want to use antibiotic.
- Is the context about the environment or biology? If yes, then you probably want to abiotic factor.
If you come across the word antibiotic or abiotic and aren’t sure which is meant, put your newfangled word knowledge to use:
- Take off the biotic portion of the word.
- What prefix remains, anti- or a-?
- Remember that antibiotics fight harmful bacteria: they are anti bacteria.
One other trick:
- If you make antibiotic or abiotic plural, does it still make sense?
- We often use antibiotics in the plural
- We generally don’t use abiotic as a plural noun, abiotics
Antibody vs. antigen
Two other words that come up in the context of disease are antibody and antigen—and yes, they are easy to get mixed up with antibiotics.
Antibodies are special proteins that the immune system produces in response to antigens. Antigens are substances that can stimulate the body’s production of antibodies.
OK, let’s break this down.
There are different types of antigens, but, for the sake of explanation, let’s focus on foreign, disease-causing antigens. These are harmful substances that come from outside the body, such as from viruses or bacteria.
The body wants to fight these off, so it recognizes these substances and starts making antibodies in the blood. These antibodies are able to latch onto the antigens using a unique binding site, which then disables the invaders.
Antibodies are also called immunoglobulins. The word antibody, recorded around 1895–1900, is based on the German Antikӧrper, with anti- meaning, yes, “against, opposing” and Kӧrper, “body.” Use of the word body here, for a molecule produced in the body, definitely makes things confusing.
Antigen is perhaps a little easier to follow, word-wise. Found in the early 1900s, antigen is shortened, in effect, form anti(body) plus -gen, a combining form meaning “producing”—in this case, producing antibodies.
Put simply, the body makes antibodies to fend off germs and other harmful substances. The body is an incredible thing—and, you know, we should all be thankful for our immune systems. That also means we should do your best to help those with compromised immune systems.